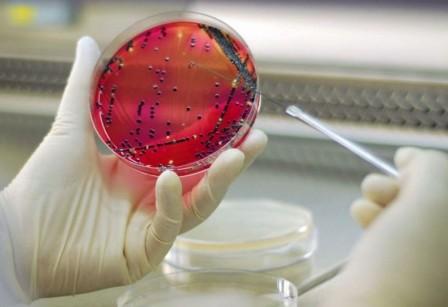

Мамандық таңдау —болашақты таңдау
Мамандық таңдау — адам өміріндегі маңызды қадамдардың бірі. Өз ісіне сенімді, дұрыс таңдау жасаған адам ғана жетістікке жетеді.
Қазіргі таңда өзекті мамандықтардың бірі— биотехнология. Биотехнологияның алғашқы нышандары адам өз өмірінде шарап сусындары мен нан-тоқаш өнімдерін дайындау да ашыту үдерісін қолданудан басталды. ХІХ ғасырда ашу үдерісі микроорганизмдердің тіршілік қызметінің нәтижесінде жүзеге асатыны белгілі болғанда биотехнология ғылым ретінде қалыптасты.Бүгінгі таңда биотехнологиялық әдістер мен тәсілдер медицина, экология, ауылшаруашылығында кең қолданылады. Осындай ғылым саласы адамзатқа ауруларды емдеу және алдын алу үшін дәрілік препараттар, ауылшаруашылығында өсімдіктердің жаңа сұрыптарын, сонымен қатар дәрумендер мен антибиотиктер және т.б. сыйлады.
Биотехнологтің қызметін қысқаша сипаттау мүмкін емес. Ол медицина, фармацевтика, гендік инженерия салаларын толық қамтиды. Әрине,биотехнолог маманның құзыреттілік деңгейі кең. Ол әртүрлі тағам өнімдерін, биологиялық белсенді заттарды, ферменттерді,антибиотиктерді өндіру биотехнологиясындағы білімді игереді. Кәсіби биотехнолог фармацевтикалық, парфюмериялық, тағам өндірісі, ветеринарлық, өндірістің өңдеуші салаларында сұранысқа ие.
Еліміздің индустриалды-инновациялық даму стратегиясына сәйкес биотехнология мемлекетіміздің экономикасын дамытуда келешегі мол сала ретінде анықталған. Биотехнология —болашақтың ғылымы. Биотехнология іргелі биологиялық білімдерді адамның практикалық қызметінде қолдануға және табиғи қорларымыздың жойылып кетпеуін сақтауға негізделген ғылым мен өндірістің жаңа саласы.Биотехнология — іргелі және қолданбалы ғылымдар мен өндірісті біріктіретін жалғыз ғылым. Оның даму нәтижесі адам өмірінің сапасын жоғарылату үшін аса маңызды болып саналады.
Елімізде биотехнолог мамандарды даярлауда көшбасшы ғылым ордасы —Әл-Фараби атындағы Қазақ Ұлттық университеті. Аталған оқу ордасында биология және биотехнология факультетінің биотехнология кафедрасы талай түлекті білім нәрімен сусындатты. Биотехнология мамандығы (5B070100) клеткалық және молекулалық биотехнология, тағамдық биотехнология, микроорганизмдер биотехнологиясы, қоршаған орта биотехнологиясы болып жіктеледі.
Биотехнология кафедрасы биотехнология мамандығы бойынша жоғары кәсіби білікті мамандар даярлау үшін бірқатар іс-шара жүргізуде. Мысалы, жұмыс берушілерге, бітірушілерге арналған сауалнамалар әзірленіп, олардың нәтижелері бойынша бакалавр, магистр деңгейлеріне арналған құзыреттердің жүйесі өңделуде. Жүйе негізінде биотехнология кафедрасы тәжірибеге бағытталған оқыту әдістерін қолдану мақсатында бірқатар кәсіпорынмен («Фудмастер», «Агропродукт», «Райымбек Боттлерс», «Бахус», «Данон» және т.б.) келісімшарттар жасады. Осы шарттар негізінде болашақ биотехнологтер өндірісте әдіс-дағдыларды жетілдіреді және жаңа өндірістік технологиялармен жұмыс жасау тәжірибелерін меңгереді.
Сонымен,Әл-Фараби атындағы Қазақ Ұлттық университетінің биотехнология кафедрасығылым, білім және бизнестің интеграциялық байланыстарын жетілдіру арқылы жоғары білікті биотехнолог мамандарды даярлап қана қоймай, еліміздің индустриалды-инновациялық дамуы үшін де өз үлесін қосады. Ел ертеңі — жас ұрпақ,ел болшағы сізбен біздің қолымызда болғандықтан, мамандық таңдауда жаңылыспайық!
Р.СЫДЫҚБЕКОВА,
Әл-Фараби атындағы Қазақ Ұлттық университеті
биология және биотехнология факультеті,
биотехнология кафедрасының биотехнология
ғылымының кандидаты, доценті.
Н.АКМУХАНОВА,
биотехнология ғылымының кандидаты.




